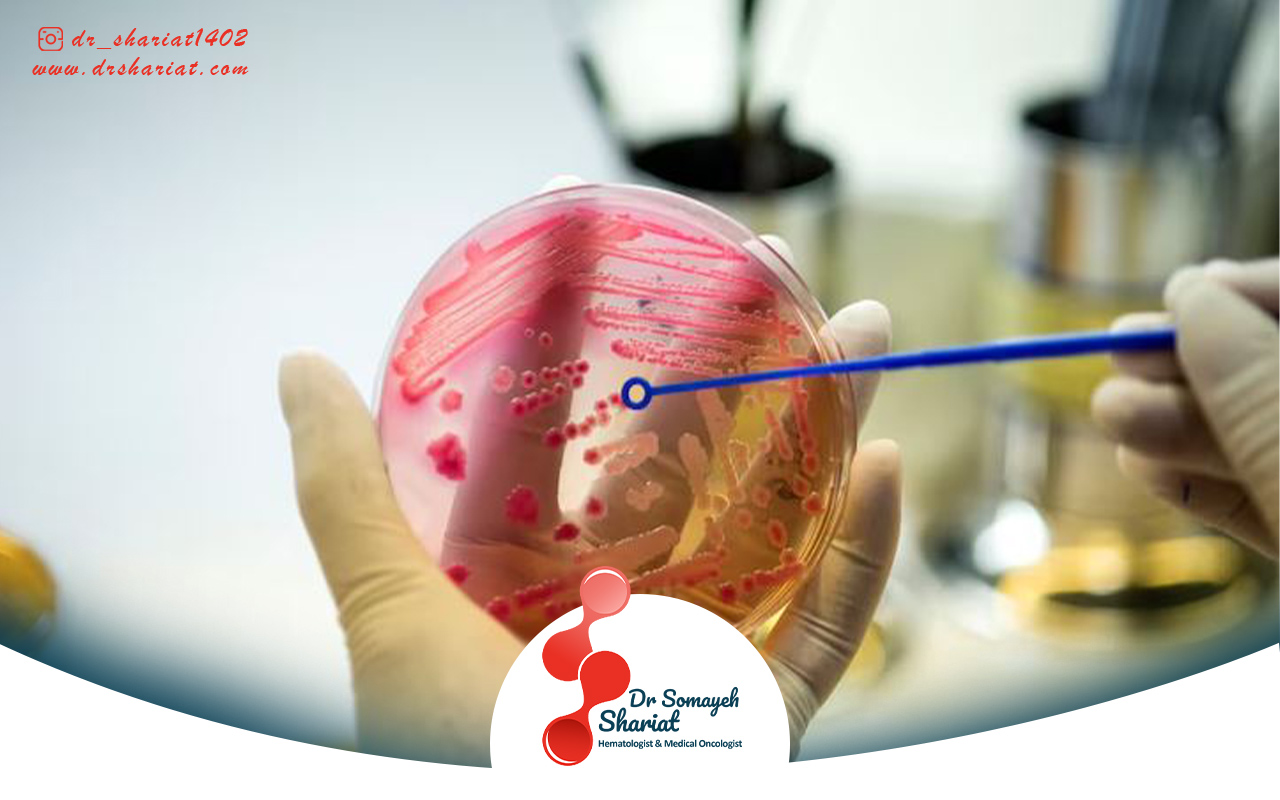
مزایا و محدودیت های درمان سرطان با سلول های بنیادی

نقش سلول های بنیادی در درمان سرطان ها
سرطان از جمله بیماری های خطرناکی است که احتمالاً با شنیدن نام آن دچار نگرانی و پریشانی بسیار زیادی خواهید شد.
فهرست مطالب
Toggleبسیاری از افراد بدون اینکه زمینه خاصی برای ابتلا به این بیماری داشته باشند گاهاً متوجه میشوند که در نقاط خاصی از بدن رشد توده های غیرطبیعی آغاز شده و باعث میشود تا این سلول های خوش خیم یا بدخیم شرایط طبیعی بدن را تغییر دهند.
خوشبختانه روش های درمانی مختلفی برای بهبود و کنترل سرطان وجود دارد.
محققان بر این باورند که سلول های بنیادی انقلابی در درمان انواع سرطان ایجاد کرده اند و با این تکنیک می توان سرطان های پیشرفته و بدخیم را درمان نمود.
به طور کلی سلول های بنیادی سلول های خاصی هستند که توانایی تکثیر شدن یا تبدیل شدن به انواع مختلف سلول های بدن را دارند.
سلول های بنیادی در دو نوع جنینی و بالغ وجود دارند، نوع جنینی از جنین های اولیه استخراج میشود که قادر است به تمامی سلول های بدن تبدیل شوند.
سلول های بنیادی بالغ در بافت های مختلف بدن مثل مغز استخوان و خون وجود دارند که عمدتاً در ترمیم همان بافت ها مورد استفاده قرار می گیرند.
سلول های بنیادی بالغ در بازساختی و درمان بیماری هایی مثل سرطان، اختلالات خونی و آسیب های عصبی نقش کلیدی ایفا می کنند.
زمانی که تومورهای سرطانی در قسمت های مختلف بدن شکل می گیرد می توان با استفاده از سلول های بنیادی اقدام به بازسازی و جایگزینی سلول های آسیب دیده نمود.
از آنجایی که سلول های بدن توانایی ترمیم خود را ندارند و به واسطه شیمی درمانی و پرتو درمانی حجم آسیب ها گسترش پیدا می کند می توان از سلول های بنیادی برای ترمیم سلول های آسیب دیده استفاده نمود.
نقش مهم سلول های سرطانی در بازسازی و ترمیم بافت های آسیب دیده زمانی مشخص میشود که بیمارانی که تحت شیمی درمانی قرار می گیرند با وجود این سلول ها می توانند بازسازی مغز استخوان را تجربه کنند.
نقش دیگر این سلول ها ترمیم سلول های عصبی و بافت های آسیب دیده بر اثر پرتو درمانی است.
همچنین زمانی که عملکرد سیستم ایمنی بدن بر اثر درمان سرطان دچار ضعف شدید میشود با وجود سلول های بنیادی می توان عملکرد این سیستم مهم را احیا کرد و به روند درمان و حفظ سلامت بیماران کمک نمود.
هدف استفاده از سلول های بنیادی در شیمی درمانی و پرتو درمانی

یکی از مهمترین روش های از بین بردن سلول های سرطانی تکنیک های خاصی مثل شیمی درمانی و پرتو درمانی است.
اما متاسفانه سلول های سالم مغز استخوان با این روش های درمانی تحت تاثیر قرار گرفته و این فرایند باعث کاهش شدید سلول های خونی و ضعف سیستم ایمنی بدن میشود.
در چنین شرایطی بیماران به سلول های بنیادی نیاز مبرم پیدا می کنند، این سلول ها می توانند باعث کاهش آسیب مغز استخوان و تسریع تولید سلول های خونی جدید شوند.
بیمارانی که تحت شیمی درمانی و پرتو درمانی قرار می گیرند احتمالاً با درصد شدیدی تخریب مغز استخوان را تجربه می کنند.
مغز استخوان تنها جایی است که سلول های خونی تولید میشوند و اگر نقصی در عملکرد آن ایجاد شود قادر به ساخت سلول های خونی جدید نخواهند بود.
از این رو متخصصان با استفاده از سلول های بنیادی و پیوند این سلول ها می توانند اقدام به بازسازی مغز استخوان کرده و تولید مجدد گلبول های سفید قرمز و پلاکت ها سرعت می یابد.
اگر بیماران مبتلا به سرطان بنا به شرایط بیماری و روند درمان خود کاهش عملکرد مغز استخوان را تجربه کنند یا دچار آپلازی مغز استخوان شوند بهترین اقدام برای مهار این عارضه استفاده از سلول های بنیادی است.
یکی از اهداف مهم استفاده از سلول های بنیادی برای بیماران سرطانی افزایش مقاومت سیستم ایمنی در برابر عفونت ها می باشد.
بیمارانی که به واسطه سرطان درمان های خاصی مثل شیمی درمانی و پرتو درمانی را انجام می دهند در صورت دریافت سلول های بنیادی در برابر انواع عفونت های ویروسی، قارچی و باکتریایی ایمن میشوند.
از طرفی پیوند سلول های بنیادی یا تزریق سلول مزانشیمی به بازسازی سریع تر سلول های ایمنی کمک کرده و خطر ابتلا به عفونت را کاهش می دهد.
سلول های بنیادی نقش بسیار مهمی در درمان انواع سرطان دارند.
بیمارانی که تحت درمان قرار می گیرند برای اینکه عوارض جانبی سایر روش های درمانی را متحمل نشوند نیاز است که از سلول های بنیادی در مراحل مختلف درمان استفاده کنند.
سلول بنیادی در روند درمان این بیماری باعث میشود تا بیماران کمتر دچار خستگی، کم خونی و ضعف عمومی شوند و دوره نقاهت را برای بیماران کاهش می دهد.
سلول های بنیادی خاصیت ضد التهابی دارند کسانی که با شرایط درمانی خاص مثل پرتو درمانی دچار التهاب میشوند و تاثیر منفی بیماری را بر سلول ها و بافت های سالم متحمل میشوند می توانند با استفاده از سلول بنیادی شرایط را مهار کنند.
به طور کلی اگر بیماران مبتلا به سرطان در مراحل درمان خود تحت پیوند سلول بنیادی قرار بگیرند این اقدام باعث میشود تا میزان انرژی فرد افزایش پیدا کرده و دچار ضعف عمومی و ضعف سیستم ایمنی نخواهند داشت.
به همین دلیل این افراد در روند درمان شرایط جسمی و روانی بهتری داشته و بعد از درمان احساس خوبی خواهند داشت.
سلول های بنیادی برای درمان انواع سرطان به ویژه برای بیمارانی که دچار کم خونی شدید یا کاهش شدید پلاکت هستند بسیار مفید است.
مزایا و محدودیت های درمان سرطان با سلول های بنیادی
سرطان از آن دسته بیماری هایی است که بلافاصله بعد از تشخیص و تایید بیماری نیاز است که بیماران تحت درمان قرار بگیرند.
اینکه دکتر سمیه شریعت چه درمانی را برای کنترل و مهار این بیماری انجام دهند بستگی به وضعیت بیماران، نوع توده و روند رشد آن دارد.
اگر پزشک متوجه شود که نوع تومور بدخیم است و احتمال پیشرفت بیماری در مدت زمان کوتاه وجود دارد درمان های فشرده را انجام می دهند.
همچنین در این مرحله مهم است که تزریق سلول های بنیادی را در راس کار قرار داده تا در مراحل درمان بیمار دچار افت جسمانی نشود.
از مهمترین مزایای استفاده از سلول های بنیادی در روند بهبود سرطان می توان به امکان ترمیم و بازسازی سلول های آسیب دیده اشاره کرد.
سلول های بنیادی در روند بهبود این بیماری باعث کاهش عوارض جانبی درمان های سنتی میشود.
اگر بیماران تحت شیمی درمانی یا پرتو درمانی قرار بگیرند با وجود سلول های بنیادی شرایط جسمی بهتری را تجربه کرده و می توانند نسبت به هر نوع درمانی خوشبین باشند.
مزیت دیگر سلول های بنیادی در روند درمان سرطان مقابله با سلول های سرطانی مقاوم به درمان است.
گاهی اوقات دارو درمانی و حتی جراحی راهکار موثری برای مقابله با سلول های سرطانی مقاوم نیست.
در این شرایط بهترین اقدام تزریق یا استفاده از سلول های بنیادی است که تجربه نشان می دهد تاثیر شگفت انگیزی در نابودی سلول های سرطانی دارد.
استفاده از سلول های بنیادی در روند درمان سرطان اگرچه کارآمد و موثر است اما گاهاً محدودیت هایی وجود دارد که شرایط استفاده از آن برای همه بیماران فراهم نمیشود.
یکی از محدودیت های مهم این تکنیک درمانی هزینه های بالا و پیچیدگی فرایند درمان با سلول های بنیادی است.
همچنین ممکن است برخی از بیماران علیرغم پرداخت هزینه ها با رد پیوند مواجه شده یا واکنش های ایمنی در بدن مانع عملکرد این سلول ها میشود.
از طرفی برخی کشورها با چالش های اخلاقی و قوانین سختگیرانه مواجه هستند و ممکن است این شرایط درمان برای همه بیماران فراهم نباشد.
تاثیر سلول های بنیادی در کاهش عوارض درمان سرطان
اگرچه سلول های بنیادی نقش کلیدی در درمان انواع سرطان دارند اما در اکثر مواقع هدف استفاده از سلول های بنیادی کاهش عوارض جانبی درمان های تخصصی است.
این سلول ها به دلیل خاصیت ضد التهابی، تعدیل سیستم ایمنی و توانایی ترمیم بافت های آسیب دیده ای که دارند در بهبود شرایط بیماران سرطانی بسیار موثر هستند.
سلول های بنیادی باعث میشود تا التهابات شدید که در اندام هایی مثل سیستم گوارشی، ریه و پوست ایجاد میشود به حداقل برسد.
گاهی اوقات بیماران در روند انجام شیمی درمانی با دوز بالا دچار کاهش شدید سلول های خونی میشوند، شرایط بیماران در این موقعیت وخیم تر شده و احتمال دریافت پاسخ مثبت نسبت به درمان کمتر میشود.
در نتیجه اگر بیماران در این مرحله از سلول های بنیادی استفاده کنند می توانند آسیب هایی مثل کم خونی، ضعف ایمنی و خطر خونریزی را کاهش دهند.
فراموش نکنید که سلول های بنیادی به تنهایی نقش بسیار مهمی بر درمان سرطان دارند، فرقی نمی کند که این سلول ها به عنوان درمان استفاده شوند یا روش مکمل در کنار دیگر روش های درمانی باشد.
در هر صورت تاثیر مثبت و شگفت انگیز خود را بر بدن بیماران اعمال کرده و به پاکسازی کامل سلول های سرطانی کمک می کند.
10 پاسخ
واقعا ممنون بابت این مقاله عالی. خیلی خوب و قابل فهم توضیح داده بودین. من همیشه دنبال یه منبع مطمئن درباره درمانهای نوین سرطان بودم و این مطلب واقعا کمکم کرد. دستتون درد نکنه.
سلام وقتتون بخیر. من یه سؤال داشتم: آیا درمان با سلولهای بنیادی برای همه نوع سرطان قابل استفادهست یا فقط برای بعضی از سرطانها جواب میده؟
سلام آقای صادقی،
درمان با سلولهای بنیادی فعلاً بیشتر برای سرطانهای خون مثل لوسمی استفاده میشه. برای سایر انواع سرطان هنوز در مرحله تحقیقات هست. بهزودی شاید کاربردش گستردهتر بشه.
آیا درمان سرطان با سلولهای بنیادی عوارض خاصی هم داره؟ چون شنیدم ممکنه سیستم ایمنی بدن رو ضعیف کنه.
سلام خانم کاویانی،
بله، یکی از عوارض اصلیش تضعیف موقت سیستم ایمنی و احتمال عفونته. البته با مراقبتهای پزشکی قابل کنترل هست و بستگی به شرایط بیمار داره.
ممنون از توضیحات روشن و ساده درباره سلولهای بنیادی و کاربردشون در درمان سرطان. اطلاعات خیلی خوبی بود.
آیا سلولهای بنیادی همه نوع سرطان رو درمان میکنن یا فقط برخی سرطانها؟
در حال حاضر درمان با سلولهای بنیادی بیشتر برای سرطانهای خون مثل لوسمی کاربرد داره و در سایر سرطانها هنوز در مراحل تحقیقیه.
عوارض احتمالی استفاده از سلولهای بنیادی در درمان سرطان چیه؟
ممکنه عوارضی مثل رد پیوند، عفونت یا واکنشهای سیستم ایمنی ایجاد بشه ولی با مراقبتهای پزشکی کنترلپذیره.